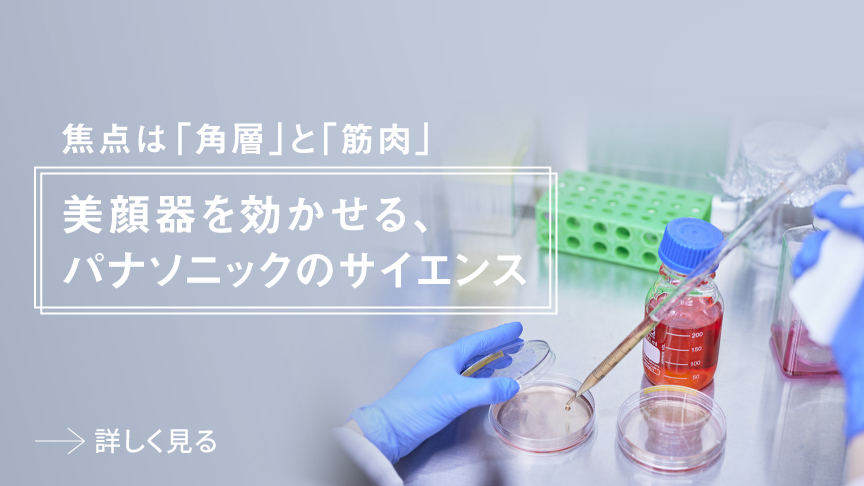
焦点は「角層」と「筋肉」,美顔器を効かせる、パナソニックのサイエンス

スキンアクト スチーマー マルチ EH-SB50商品特長・効果


ナノサイズ濃密スチームと化粧水ミストのダブル保湿で、
うるおいに満ちた生ツヤ肌に
温スチームを浴びて、水分を含みもっちりふっくらとした肌の表面に、微細な化粧水ミストを浴びることで、保湿成分が角層まですばやく浸透。


ナノサイズ濃密スチーム
×
化粧水ミスト
ダブル保湿のしくみ

①肌のバリア機能があり、水分が入りづらい。

②温スチームをしっかり浴びると、角層細胞が水分を含み、肌がふっくら。うるおいをため込みやすい状態に。

③角層細胞が水分で十分満たされた肌は、微細な化粧水ミストがぐんぐん浸透。水分と保湿成分が角層まで浸透しやすく。
顔全体を包み込む、
パナソニックこだわりの
ナノスチームテクノロジー
やかんの湯気よりも格段に微細なスチームで、顔全体を包み込む。肌も心もうるおうような、やさしい浴び心地。

温スチームの方が非常に細かく、高密度。
【比較方法】
EH-SB50と性能が同等の当社従来品2020年発売EH-SA0Bの温スチーム・やかんの湯気が付着したアクリル板を120倍ズームで撮影。
- 当社調べ
- 効果には個人差があります
スチーム研究50年以上
きめ細かく、ふわっと広がるこだわりのスチーム
うるおいはいつの時代も重要。1970年に初代スチーマーを発売して以来、お客様のニーズや生活シーンに寄り添い、開発。


温スチーム(約12分)1回の使用で目立つ黒ずみ毛穴個数の減少

【モデル試験方法】単回
洗顔後に測定
EH-SB50と性能が同等の当社従来品2020年発売EH-SA0Bの温スチーム12分間使用
【測定部位】全顔
【試験方法】ロボスキンアナライザーによる測定
【被験者】20代~40代 女性10名
*黒ずみ毛穴とは黒ずみが目立つ毛穴のこと
- 当社調べ
- 効果には個人差があります
温スチーム+化粧水ミストで、
手塗りと比べて角層への保湿成分の浸透が約15%アップ※1
手で塗るよりも、保湿成分が角層までしっかり浸透。

【モデル試験方法】単回
EH-SB50と性能が同等の当社従来品2020年発売EH-SA0Bの温スチーム12分間使用、オリゴペプチド水溶液をミスト化して塗布
- 当社調べ
- 実際の肌での試験ではありません。
- 皮膚サンプルを使用
顔の隅々までたっぷり保湿

連続的に出る微細ミスト化した化粧水が、顔全体に広く均一に。
【比較方法】
手塗り、コットン、EH-SB50と性能が同等の当社従来品2020年発売EH-SA0Bの化粧水ミスト機能での噴霧を10名で実施し比較。
全て同量の液体を塗布(人体に影響のない液体を使用)。
- 当社調べ
- 効果には個人差があります
お手持ちの化粧水が使える

専用の化粧水は不要。普段お使いのお好みの化粧水でケアできる。
- 粘度の高い化粧水は、ミストの粒が大きくなったり、噴霧できない場合があります。
- 医薬部外品や拭き取り化粧水は、化粧品が指定する用法と異なるため使用しないでください。
- 酸化チタン、酸化亜鉛、シリカ、酸化鉄、白金を含んだ化粧水、固形物を含んだ化粧水は使用しないでください。
1回でもさまざまな
肌効果を実感
さらに2週間、4週間
使うたび実感


【モデル試験方法】
洗顔後、MOISTモード使用後にお手持ちの化粧水をミスト噴霧
「機器未使用」「初回使用」「2週間使用後」「4週間使用後」の比較
【測定部位】全顔
【被験者】20~40代 女性 20名
- 当社調べ
- 効果には個人差があります
温冷ギャップで
キュッと引き締まった肌へ

温スチームと冷ミストを自動で交互に浴びられるモードを搭載。急速な温冷の温度差による刺激で、みずみずしく明るい、透明感※2のある肌へ。ボタンひとつで、スペシャルケア。
「ハリ感」や「毛穴の目立ちにくさ※2」も2週間、4週間、使うたび実感


【モデル試験方法】
洗顔後、ENRICHモード使用
「機器未使用」「初回使用」「2週間使用後」「4週間使用後」 の比較
【測定部位】全顔
【被験者】20~40代 女性 20名
- 当社調べ
- 効果には個人差があります
ディープクレンジングで
メイク汚れが落ちやすく※3
クレンジングをするときに温スチームを浴びると、メイクが浮き上がるので、ベースメイクや、しっかりつけたマスカラも落ちやすく※3。

【モデル試験方法】単回
CLEANモード使用
【測定部位】全顔
【被験者】20~40代 女性 20名
- 当社調べ
- 効果には個人差があります

【モデル試験方法】
マスカラを塗布したつけまつげにスチームを約3分間あてた後、クレンジング剤をつけてコットンで5回拭いた場合
40 ℃のスチームを浴びると、
肌温度が上昇
【モデル試験方法】ダブルスチーム搭載EH-SB50と当社2023年発売シングルスチーム搭載EH-SA3Dを使用し、温スチーム12分間使用後に測定
【測定部位】全顔
【試験方法】サーモグラフィーカメラによる測定
- 当社調べ
- 効果には個人差があります。
温スチームで約3分。
スチームでメイクを浮き上がらせて取れやすく※3
STEP1. 【MOIST/CLEAN】を選択し、約3分間温スチームを浴びる(手動停止)。
STEP2. ティッシュなどで水気を軽く取る(水気が残っているとメイクが落ちにくくなることも)。
STEP3. クレンジング剤をなじませる。
*週に1~2日が目安
なりたい肌にあわせて選べる5つのモード


BRIGHTモード
温スチームと冷ミストを交互に浴びて、みずみずしく明るい、透明感※2のある肌へ。


ENRICHモード
スチームで肌をしっかり温めた後、冷ミストで急速冷却。毛穴の目立ちにくい※2引き締まったハリ感のある肌へ。


MOISTモード
温スチームが顔全体を包み込み、うるおいに満ちた肌へ。


CLEANモード
ディープクレンジングに。
*週に1~2日が目安


MISTモード
お手持ちの化粧水または水をミスト化。顔の隅々までたっぷり保湿。



①化粧水ミスト
ダブル保湿したいときに。他のモードの仕上げにも。普段お使いの化粧水をミスト化
- 化粧水ミストタンクは、温スチーム使用時は取り付けず、化粧水ミストを使用する直前にセットしてください。温スチーム発生時に化粧水ミストタンク内が温まる可能性があります。
- ご使用の際はミストボタンを押し続けてください。ボタンから指を離すとミストは停止します。
- 付属の化粧水専用「化粧水ミストタンク」をご使用いただくため、温スチームの温度で化粧水が噴霧されることはありません。

②冷ミスト
引き締め整えたいときに。他のモードの仕上げや、お風呂上がり・夏などクールダウンしたいときにも
- ご使用の際はミストボタンを押し続けてください。ボタンから指を離すとミストは停止します。
美顔器と併用のスペシャルケアも


使用者の声
*弊社からモニターに依頼し、頂いたコメントを編集して掲載しています。

肌がふっくらもっちりした。スキンケア品がぐんぐん肌に浸透※4していくようになってきた。
(Aさん 29歳女性)

化粧水ミストを馴染ませるだけで肌に艶が出てツルツルした感じがする。化粧水の浸透※4が良く、普段つけている量よりも沢山肌が吸収している感じがした。乳液を付けた後の肌の手触りもモッチリ。
(Bさん 33歳女性)

肌の調子が良さそうだねとよく言われるようになった。基礎化粧品の肌への浸透※4が良くなったように思う。化粧ノリもとてもよく、ファンデのヨレも目立っていたのに、それがなくて驚いた。毎日スチームするだけでこんなに違うんだとびっくり。毛穴も目立ちにくくなった。
(Cさん 36歳女性)
【モデル試験方法】
「機器未使用」「初回使用」「2週間使用後」「4週間使用後」 の比較
A、B:洗顔後、MOISTモード使用後にお手持ちの化粧水をミスト噴霧
C:洗顔後、ENRICHモード使用
【測定部位】全顔
【被験者】20~40代 女性 各モード20名
- 当社調べ
- 効果には個人差があります
NEW 効率的なスキンケアルーティンをサポート
<iPhoneのみ対応>
NEW 2025年10月10日 追加予定


- iOS、iPhoneは、米国および他の国々で登録された Apple Inc. の商標です。iPhoneの商標は、アイホン株式会社のライセンスに基づき使用されています。
70,000点以上の写真データから学習したAI※5が肌状態を分析。
- 肌タイプやその日の天候にあわせて、おすすめのモードをご提案
- NEW スチーマーを浴びながらできる、表情筋トレーニング動画をご用意
- NEW 月に一度、スチーマーのメンテナンスを通知お知らせ
美しさと使い勝手を追求したデザイン
従来製品よりも18%小型化※6。
置きっぱなしでもインテリアになじむシンプルデザイン


白を基調に丸みを帯びたボディで、空間において圧迫感を軽減。よりくらしになじみやすいデザインへ。
実際のサイズ感をスマホで見る
AR設置シミュレーション
- 商品画像はイメージです


本機能はパソコンではご利用いただけません。
スマートフォン・タブレットで下のQRコードを読み込んでお試しください。
動作環境
- iOS・iPadOS 12以降のSafari
- Android 8.0以降のChrome
注意事項
- AR機能による家電製品の配置はあくまで設置イメージとなります。
- ご購入前には実際の寸法をご確認ください。
- 空間を認識しづらい場合は、物が置かれていない平らな面や、部屋を明るくしてお試しください。
- 対応デバイスでもご利用環境によって正常に動作しないことがあります。
- 以下、iOS(18.5)の見え方で説明しております。
- OSやOSのバージョンによって見え方が一部異なります。
- iOSの場合はSafariでの閲覧を推奨いたします。
①AR設置シミュレーション起動ボタンをタップしてビューアーを起動

②ARモードで商品画像を配置する
画面上部で「ARモード」になっていることを確認。
スマートフォンを動かして画像を表示させたい平面を読み込んでください。カメラで写した場所に商品画像が表示されます。
4秒ごとに、外蓋が自動で開閉します。
*お部屋はできるだけ明るくしてください。
**スマホ・タブレットの本体画面は縦向きでもご利用いただけます。

③商品画像の位置を調整する
位置を移動させるときは1本指で。
本体の向きを回転させるときは2本指で。


【ご利用にあたっての注意事項】
- AR機能での配置イメージはあくまでシミュレーションとなります。シミュレーション結果は実際のサイズと異なる可能性があります。ご購入前には実際の寸法をご確認くださいますよう、お願い致します。
- 空間を認識しづらい場合は、物が置かれていない平らな面や、部屋を明るくしてお試しください。
- AR機能をご利用するにあたっては、周囲に十分注意の上、ご利用いただくようにお願い致します。
- ご利用の際はWi-Fi環境を推奨します。
- 通信費はお客様のご負担となりますのでご了承ください。
使いやすさを追求

スチーム吹出口を低めに設定。ノズル角度調整によって、さまざまな体格や使用場所に対応。
スチームの質や、使いやすい安心配慮設計を支える
パナソニック独自の特許


比較表
おすすめコンテンツ
- EH-SB50と性能が同等の当社従来品2020年発売EH-SA0Bの温スチーム12分間使用後に、グリセリン水溶液を化粧水ミストとしてあてた場合の浸透量25.3 μg/cm2、グリセリン水溶液をコットンに含ませて、手で塗布した場合の浸透量21.8 μg/cm2 前腕での比較(当社調べ)
- キメが整うことによる肌の見え方
- クレンジング剤、メイクの種類によっては落ちにくい場合があります。
- 角層まで
- パーフェクト株式会社のAI肌診断機能を搭載
- 当社従来品2020年発売EH-SA0B比較(当社調べ)
・効果には個人差があります。
・商品使用シーン写真、イラストはイメージです。
・製品の定格およびデザインは改善等のため予告なく変更する場合があります。
掲載商品の価格には、配送・設置調整費、工事費、使用済み商品の引き取り費等は含まれておりません。